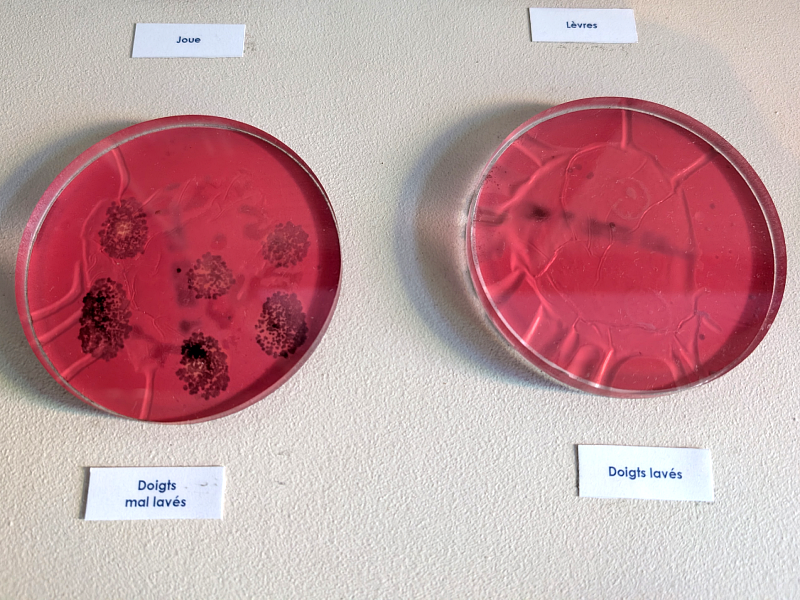

J’ai deux héros dans la vie : Marie Curie et Louis Pasteur.
Si la première n’a jamais mis les pieds à Lille, le second y a créé en 1895 un institut qui porte son nom.
En 2017, le petit musée poussiéreux qui existait depuis des années a été métamorphosé en un endroit magnifique, original et très intéressant que je vous suggère réellement de découvrir !
Article mis à jour le 22 avril 2026
Professeur de chimie, Louis Pasteur est venu à Lille pour étudier la levure de bière. Et où mieux étudier la bière que dans le Nord ? 😉 Pasteur, qui s’intéressait à la fermentation depuis 1849, avait reçu des demandes de brasseurs lillois concernant la conservation de leur précieux liquide. Devenu premier doyen de la faculté des sciences de Lille de 1854 à 1857, Pasteur y a mis au point les bases de la microbiologie moderne avec l’aide des brasseurs et des distilleurs de betteraves à sucre.

En 1894, une importante épidémie de diphtérie a frappé la ville de Lille. Des élus locaux se sont rendus à l’Institut Pasteur de Paris pour y rencontrer le Docteur Emile Roux, qui venait de publier des travaux sur la diphtérie ainsi que sur le sérum qu’il venait de mettre au point.
Ces élus voulaient créer à Lille un bureau d’hygiène pour empêcher de nouvelles épidémies, mais aussi un centre de production de sérum antidiphtérique et un centre antirabique. C’est Emile Roux, proche collaborateur de Louis Pasteur, qui a eu l’idée de créer un institut à Lille. Il a été inauguré en 1899. Avant son décès, Pasteur en a confié la direction au docteur Albert Calmette.

À Lille, les médecins et hygiénistes dénonçaient la mauvaise qualité de l’eau et plus particulièrement les canaux à ciel ouvert où se mélangent eaux propres et usées, générant d’importantes épidémies (typhus, typhoïde, choléra) et une mortalité considérable.
Des établissements tels que la Piscine de Roubaix ont été ouverts pour que les habitants de la métropole puissent nager, mais aussi se laver dans une eau propre. Et la toute première station d’épuration biologique en France a été installée en 1906 par le professeur Calmette, directeur de l’Institut Pasteur, à La Madeleine, le long de la Deûle.


Installé en 2017 dans les anciens appartements d’Albert Calmette, le musée de l’Institut Pasteur bénéficie d’une nouvelle scénographie plus moderne et plus attrayante.

La visite de ce bâtiment, où le temps semble s’être arrêté à la fin du 19e siècle, vous permet d’être le témoin de découvertes scientifiques historiques : les bases de la microbiologie moderne, la production d’un sérum contre la diphtérie, le vaccin contre la rage, celui contre la tuberculose…


Au début de sa carrière scientifique en tant que chimiste, Pasteur a résolu en 1848 un problème fondateur de la chimie contemporaine : la séparation des deux formes de l’acide tartrique.

Ses contemporains ne parvenaient pas à distinguer deux composés ayant la même formule, l’acide tartrique (issu de la vinification) et l’acide paratartrique. Pasteur, en réexaminant les cristaux, a remarqué une dissymétrie : le tartrate ne montre qu’une seule forme, tandis que le paratartrate contient deux types de cristaux en images miroir.
Tout ça pour dire que les travaux de Pasteur dans ce domaine ont abouti, quelques années plus tard à la naissance du domaine de la stéréochimie, qui a grandement contribué à l’essor de la chimie organique moderne.

La scénographie proposée pour le musée de l’Institut Pasteur associe art et science, histoire et modernité, poésie et nouvelles technologies. Le musée utilise des vidéos, des projections, des objets interactifs que vous pouvez tirer, pousser ou attraper… Une découverte à la fois ludique et instructive vous attend.


La souris est une projection. À l’époque de Pasteur, on pensait que les rats et les souris naissaient spontanément « de la saleté » !

Pasteur, grâce à ses expériences avec des ballons à col de cygne et sa découverte de la pasteurisation, a pu invalider cette théorie de la « génération spontanée ». Il a clairement établi qu’il y avait toujours des germes, des contaminations, à l’origine des êtres vivants apparus. La remise en cause de cette génération spontanée a permis de souligner l’importance des mesures d’hygiène et d’asepsie contre le développement des maladies.

Evidement, on ne peut passer à côté de la découverte la plus célèbre de Louis Pasteur, celle du vaccin contre la terrible maladie de la rage. Entre 1879 et 1885, le scientifique a travaillé sur le virus en lui-même et sur sa transmission, a expérimenté sur des moutons, des chiens et des lapins, et a finalement réussi à créer une forme du virus atténuée.
Une vidéo raconte l’histoire du petit Joseph Meister, 9 ans, qui avait été mordu par un chien enragé et qui a été sauvé par le vaccin expérimental mis au point par Pasteur.





La présentation officielle du musée indique : « Le musée de l’Institut Pasteur à Lille a été créé pour rendre hommage à ses pères fondateurs, chercheurs talentueux et humanistes dont le travail a permis de sauver des millions de vies dans le monde : Louis Pasteur, Albert Calmette et Camille Guérin. C’est dans ces murs que Calmette et Guérin ont découvert le BCG, vaccin contre la tuberculose, dont les souches originales sont présentées dans ce musée. C’est aussi l’histoire de la fermentation alcoolique découverte par Pasteur à la Faculté des Sciences de Lille quand il était doyen en 1854 et le vaccin contre la rage en 1885. »

La plus grande découverte faite à l’Institut Pasteur de Lille est sans conteste la découverte du « Bacille de Calmette – Guérin ». Le biologiste Albert Calmette et le vétérinaire Camille Guérin ont mené ensemble des recherches sur un vaccin contre la tuberculose, une maladie mortelle qui faisait des ravages.


En 1921, ils sont parvenu à modifier une souche de mycobacterium bovis (bacille de Koch) en la cultivant sur des tranches de pommes de terre. Ils ont ainsi mit au point le « BCG », le vaccin le plus utilisé au monde.






La visite est libre, guidée en totale autonomie avec l’application Wivisites, audioguide gratuit sur votre smartphone.
Si vous le pouvez, je vous recommande de réserver une visite guidée par le biais de l’Office du tourisme de Lille. Elle en vaut réellement la peine, car les explications, qui offrent la juste dose de science, d’anecdotes et d’histoire, vous ouvrent en grand les portes de l’univers des formidables chercheurs qu’étaient Pasteur et Calmette.


La visite se termine par une petite pièce qui met en valeur les recherches des laboratoires nordistes ANIOS (qui ont financé la création de ce nouveau musée). Vous pouvez glisser vos mains dans un appareil qui met en lumière les bactéries ou regarder des (faux) microbes dans un microscope.

Reconnu d’utilité publique, l’Institut Pasteur de Lille fait à présent partie du Réseau international des instituts Pasteur. Il est associé à l’Université de Lille, au CHU de Lille, à l’Inserm et au CNRS.


INFORMATIONS PRATIQUES
Adresse : 18 Boulevard LouisXIV à Lille.
Le musée est situé juste en face de la station de métro « Lille Grand Palais » (ligne 2).
Ouverture au public : Samedi et dimanche : 10h – 12h / 14h – 17h
Ouverture aux groupes (sur réservation) : Du lundi au vendredi
Tarifs
Plein : 6€
Réduit : 3€ (12-25 ans, étudiants, demandeurs d’emploi, personnes en situation de handicap)
Gratuit : moins de 12 ans et détenteurs de la carte City-Pass
Informations / Réservations : 03 20 87 72 42 et musee[@]pasteur-lille.fr
L’Institut Pasteur de Lille est indépendant financièrement, les subventions ne représentent que 25 % de ses ressources. Les dons, legs et mécénats sont donc très importants et financent la recherche fondamentale. Chaque année, l’Institut effectue 40 000 vaccinations, près de 13 000 bilans de santé, 5 000 consultations spécialisées avant les voyages, 500 000 analyses médicales.
N’hésitez pas à faire un don !
Cet article vous a plu ? Gardez-le ou partagez-le.



